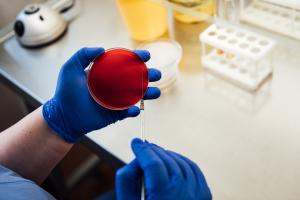

-
Услуги КонсультацииДиагностикаКДО №1 (г. Новосибирск, ул. Речкуновская д. 15)
Режим работы:
Пн,Вт,Ср,Чт,Пт
08:00-20:00
+7 (383) 328–10–40Консультативно-диагностическое отделение (г. Новосибирск, ул. 1905 года д. 83)
Режим работы:
Пн,Вт,Ср,Чт,Пт
08:00-20:00
+7 (383) 328–10–40Радиологический корпус (г. Новосибирск, ул. Речкуновская, 15 к1)
Режим работы:
Пн,Вт,Ср,Чт,Пт
08:00-20:00
+7 (383) 328–10–40 -
Для пациента Как попасть на прием и лечениеГоспитализация от А до Я
- Подготовка к госпитализации
- Дата госпитализации
- Перенос даты госпитализации
- Правила внутреннего распорядка и условия пребывания в центре
- Что взять с собой на госпитализацию
- Длительность госпитализации
- Правила поведения пациента в Центре
- Узнать о состоянии пациента
- Посещение пациентов и прием передач
- Пансионат на территории Центра
- Госпитализация сопровождающих лиц
Правовая и полезная информацияКДО №1 (г. Новосибирск, ул. Речкуновская д. 15)
Режим работы:
Пн,Вт,Ср,Чт,Пт
08:00-20:00
+7 (383) 328–10–40Консультативно-диагностическое отделение (г. Новосибирск, ул. 1905 года д. 83)
Режим работы:
Пн,Вт,Ср,Чт,Пт
08:00-20:00
+7 (383) 328–10–40Радиологический корпус (г. Новосибирск, ул. Речкуновская, 15 к1)
Режим работы:
Пн,Вт,Ср,Чт,Пт
08:00-20:00
+7 (383) 328–10–40 -
Клиника КардиохирургияНейрохирургияМедицинская реабилитацияКДО №1 (г. Новосибирск, ул. Речкуновская д. 15)
Режим работы:
Пн,Вт,Ср,Чт,Пт
08:00-20:00
+7 (383) 328–10–40Консультативно-диагностическое отделение (г. Новосибирск, ул. 1905 года д. 83)
Режим работы:
Пн,Вт,Ср,Чт,Пт
08:00-20:00
+7 (383) 328–10–40Радиологический корпус (г. Новосибирск, ул. Речкуновская, 15 к1)
Режим работы:
Пн,Вт,Ср,Чт,Пт
08:00-20:00
+7 (383) 328–10–40 -
Образование Сведения об образовательной организации
- Основные сведения
- Структура и органы управления
- Документы
- Образование
- Образовательные стандарты
- Руководство. Педагогический (научно-педагогический состав)
- Материально-техническое обеспечение и оснащенность образовательного процесса
- Стипендии и иные виды материальной поддержки
- Платные образовательные услуги
- Финансово-хозяйственная деятельность
- Вакантные места для приема (перевода) обучающихся
- Доступная среда
- Международное сотрудничество
- Конкурс на замещение должностей педагогических работников
Ординатура- Общая информация
- Приемная кампания 2026/2027
- Подать документы на обучение в ординатуре
- Информация о поданных заявлениях
- Приказы о зачислении
-
Целевое обучение в ординатуре и аспирантуре
АспирантураДополнительное профессиональное образование- Виды дополнительного образования
- Программы повышения квалификации и профессиональной переподготовки
- Расписание обучения
- Оформление на обучение с оплатой физическим или юридическим лицом
- Оформление на обучение при оплате обучения из средств государственного бюджета
- Оформление участия в мероприятии в форме семинара (тренинга) с оплатой физическим или юридическим лицом
- Анкета для студентов медколледжа
Аккредитация специалистов- Общая информация об аккредитации специалистов
- Сведения об аккредитационном центре
- Первичная аккредитация специалистов
- Первичная специализированная аккредитация специалистов
- Протоколы АПК по специальности «Сердечно-сосудистая хирургия»
- Периодическая аккредитация специалистов
- Подготовка к прохождению аккредитации специалистов
- Получение результатов аккредитации специалистов и апелляция
- Документы, регламентирующие проведение аккредитации специалистов
КДО №1 (г. Новосибирск, ул. Речкуновская д. 15)
Режим работы:
Пн,Вт,Ср,Чт,Пт
08:00-20:00
+7 (383) 328–10–40Консультативно-диагностическое отделение (г. Новосибирск, ул. 1905 года д. 83)
Режим работы:
Пн,Вт,Ср,Чт,Пт
08:00-20:00
+7 (383) 328–10–40Радиологический корпус (г. Новосибирск, ул. Речкуновская, 15 к1)
Режим работы:
Пн,Вт,Ср,Чт,Пт
08:00-20:00
+7 (383) 328–10–40 -
Наука Основная информацияНаучные подразделения
- НИО хирургии аорты, коронарных и периферических артерий
- НИО новых хирургических технологий
- НИО хирургической аритмологии
- НИО эндоваскулярной хирургии
- НИО сосудистой и гибридной хирургии
- НИО онкологии и радиотерапии
- НИО ангионеврологии и нейрохирургии
- НИО анестезиологии и реаниматологии
- НИО лучевой и инструментальной диагностики
- Институт онкологии и нейрохирургии
Подготовка диссертацийДиссертационные советы- Требования к соискателям
- ГОСТ по оформлению диссертации и автореферата
- Контакты совета
-
Диссертационный совет 21.1.027.01
-
Диссертационный совет 21.1.027.02
-
О Центре Общая информацияОрганизационно-методическая службаДокументы и отчетыСотрудничествоКонтакты и реквизиты
-
Часто задаваемые вопросы Вопросы по госпитализации
- Узнать о состоянии пациента
- Куда приехать для госпитализации в Центр
- Перенос даты госпитализации при ухудшении состояния
- Госпитализация пациентов детского возраста (до 18 лет)
- Согласование даты госпитализации
- Перечень документов для госпитализации пациента
- Перечень обязательных анализов и обследований перед госпитализацией пациента
- Что из личных вещей взять с собой для госпитализации
- Длительность госпитализации
- Посещение пациентов и прием передач
- Проживание для иногородних пациентов и сопровождающих лиц
Другие вопросы- Запись на амбулаторный прием и диагностические обследования
- Подготовка к амбулаторным диагностическим исследованиям
- Как получить квоту на оказание ВМП
- Информация о талоне ВМП
- Пропуск автомобиля и парковка
- Как получить справку об оплате медицинских услуг для представления в налоговые органы РФ
- Жалоба на самочувствие после выписки
- Можно ли заказать транспортировку пациента
- Когда пациент находится в другой медицинский организации